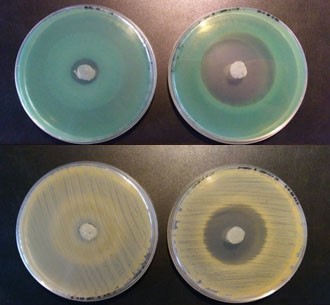

Medicina
Sin adoptar medidas, el cáncer crecerá un 60% en los próximos veinte años
Con ocasión del Día Mundial contra el Cáncer, la Organización Mundial de la Salud ha advertido que, si las tendencias actuales continúan, el mundo verá aumentar los casos de esta enfermedad en un 60% en las próximas dos décadas.
La mayor subida de nuevos casos, alrededor del 81%, ocurrirá en países de ingresos bajos y medianos, donde las tasas de supervivencia son actualmente más bajas.
Esto se debe principalmente a que estos países han tenido que concentrar sus limitados recursos de salud en combatir enfermedades infecciosas y en mejorar la salud materno-infantil, mientras que sus servicios sanitarios no están equipados para prevenir, diagnosticar y tratar el cáncer.
En 2019, más del 90% de los países de altos ingresos informaron que los servicios de tratamiento integral para el cáncer estaban disponibles en el sistema de salud pública en comparación con menos del 15% de los países de bajos ingresos.
"Este es un llamado de atención a todos nosotros para abordar las desigualdades inaceptables entre los servicios de cáncer en los países ricos y pobres", ha asegurado el doctor Ren Minghui, alto responsable de la OMS.
"Si las personas tienen acceso a la atención primaria y los sistemas de derivación, entonces el cáncer puede detectarse temprano, tratarse eficazmente y curarse. El cáncer no debería ser una sentencia de muerte para nadie, en ningún lugar ", añadió.
![[Img #58963]](https://noticiasdelaciencia.com/upload/images/02_2020/3571_image1170x530croppedffd4.jpg)
Asistentes de laboratorio sobre el Virus del Papiloma Humano y el Instituto de investigación sobre el Cáncer en Colombia. (Foto: OMS/OPS//Jane Dempster)
El avance contra la enfermedad en los países más pobres es alcanzable. La Organización Mundial de la Salud y el Centro Internacional de Investigación sobre el Cáncer (IARC) han publicado dos informes simultáneos en este Día Mundial con el Cáncer, en respuesta a llamados de distintos Gobiernos para que se investigue el alcance de posibles políticas y programas para mejorar el control de esta dolencia.
"Mediante la identificación de las políticas más apropiadas de acuerdo con la situación de cada país, junto a la inclusión de la respuesta al cáncer en la cobertura sanitaria universal y la movilización de las diferentes partes interesadas para que trabajen de forma coordinada, se podrían salvar al menos siete millones de vidas en la próxima década”, asegura el doctor Tedros Adhanom Ghebreyesus, director general, de la Organización Mundial de la Salud.
Esta Organización destaca que existe una amplia gama de medidas para prevenir nuevos casos de cáncer.
Entre tales medidas figuran:
controlar el consumo de tabaco, responsable del 25% de las muertes por cáncer
vacunar contra la hepatitis B para prevenir el cáncer de hígado
eliminar el cáncer de cuello uterino con la vacuna contra el virus del papiloma humano
la detección temprana y el tratamiento
"Durante los últimos 50 años se han visto enormes avances en la investigación sobre la prevención y el tratamiento del cáncer", explica la doctora Elisabete Weiderpass, directora del Centro Internacional de Investigación sobre el Cáncer.
Después de las mejoras en los tratamientos y de que los países de altos ingresos adoptaron programas de prevención, diagnóstico temprano y detección, la probabilidad de mortalidad prematura por el cáncer se ha reducido un 20% entre 2000 y 2015 en esas naciones. Sin embargo, ese porcentaje en los países de bajos solo fue del 5%.
“Necesitamos que todo el mundo se beneficie del mismo modo”, añadió Weiderpass.
El desafío para los países será identificar qué tratamientos deciden adoptar teniendo en cuenta el costo, la factibilidad y la efectividad.
Cada Gobierno tiene la tarea de elegir las terapias innovadoras apropiadas contra el cáncer, teniendo en cuenta que muchos de los tratamientos existentes son muy asequibles y efectivos contra el cáncer, sin causar dificultades financieras.
El cáncer es un proceso de crecimiento y diseminación incontrolados de células. Puede aparecer prácticamente en cualquier lugar del cuerpo. El tumor suele invadir el tejido circundante y puede provocar metástasis en puntos distantes del organismo. Muchos tipos de cáncer se podrían prevenir evitando la exposición a factores de riesgo comunes como el humo de tabaco. Además, un porcentaje importante de cánceres pueden curarse mediante cirugía, radioterapia o quimioterapia, especialmente si se detectan en una fase temprana. (Fuente: ONU)